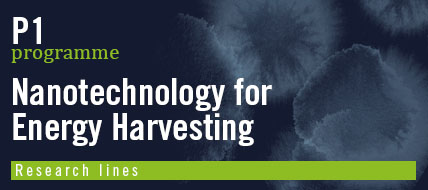
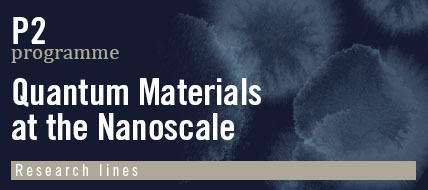

Nanocarbons and Organic Photovoltaics
Prof. Nazario Martín
Chemistry of Low Dimensional Materials
Prof. Emilio M. Pérez
Switchable Nanomaterials
Dr. José Sánchez Costa
Systems Chemistry Laboratory
Prof. Thomas Hermans
Functional Nanoscale Materials and Devices
Dr. Enrique Burzuri
Molecular Electronics
Dr. Edmund Leary
Functional Organic Materials
Prof. Tomás Torres
Scanning Probe Microscopies and Surfaces
Prof. Rodolfo Miranda
Theoretical Modelling
Prof. Francisco Guinea
Quantum Devices and Photonics
Prof. Daniel Granados
Nanoarchitectures at Surfaces
Prof. David Écija
Spin-Polarized Low Temperature STM
Dr. Fabián Calleja
Topological Surfaces States in Quantum Materials
Dr. Manuela Garnica
Applied Nanoelectronics
Dr. Ramón Bernardo
First-Principles Modelling for Quantum Materials
Dr. José Ángel Silva Guillén
On-surface Synthesis of Carbon-based Nanostructures
Dr. José Ignacio Urgel
Imaging of 2D Materials
Prof. Amadeo L. Vázquez de Parga
Photonic STM
Prof. Roberto Otero
Transport in 2D Systems
Prof. Jose Luis Vicent
Theoretical Study of Molecules on Surfaces
Prof. Manuel Alcamí
Nucleic Acids and Nanoparticles in Nanomedicine
Prof. Álvaro Somoza
Advanced Fluorescence Nanoscopy
Prof. Cristina Flors
Molecular Motors Manipulation Lab
Dr. Borja Ibarra
Magnetic Nanoparticles
Dr. Gorka Salas
Neural Interfaces
Mª Teresa González
Biosensors in Neuroscience
Dr. Valle Palomo
Protein Engineering
Dr. Begoña Sot
Intracellular Temperature Measurements
Dr. Sebastián Thompson
Engineering Biofunctional Nanostructures
Prof. Aitziber L. Cortajarena
Magnetic Nanoparticles in Biomedicine - Cell-particle Interactions
Prof. Ángeles Villanueva
Advanced Magneto-Optics
Prof. Julio Camarero
Technological and Biomedical Applications of Magnetic Nanoparticles
Dr. Francisco Terán
SpinOrbitronics
Dr. Paolo Perna
Transport in Quantum Materials
Dr. Mariela Menghini
Spin-Resolved ARPES
Dr. Miguel Ángel Valbuena
Photophysics of Organic and Hybrid Supramolecular Nanosystems
Prof. Johannes Gierschner
Pump-probe Photoinduced Absorption Spectroscopies
Prof. Juan Cabanillas
Nanooptics and Nanoacoustics
Prof. Reinhold Wannemacher
Nanostructured Photovoltaics
Dr. Enrique Cánovas
X-ray wave-mixing methods
Dr. Cristian Svetina
Modelling Physical Properties of Nanostructures
Prof. Fernando Martín
Femtochemistry
Prof. Luis Bañares
Ultrafast X-Ray Science
Prof. Wojciech Gawelda
Bio-engineered nanophotonics
Dr. Sara Hernández
Ultrafast Science of Quantum Materials
Dr. Allan Johnson